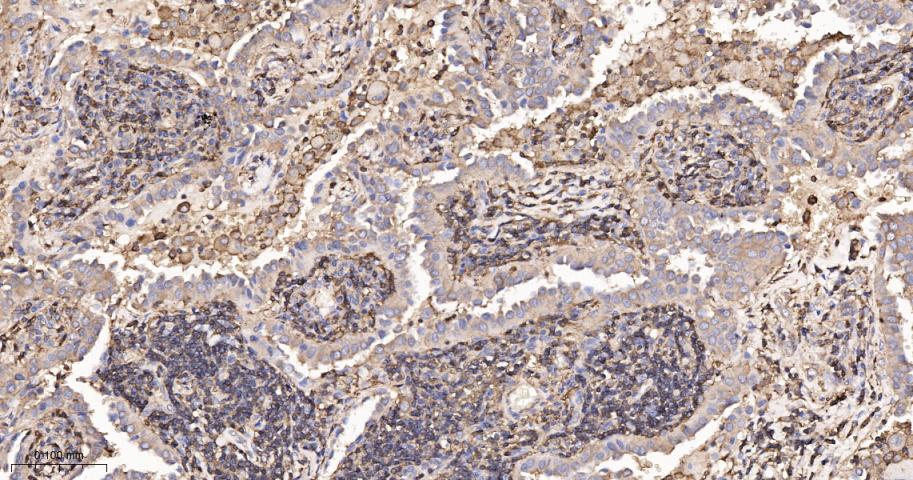
β-肌动蛋白/β-Actin(内参)抗体

beta-Actin Rabbit pAb, Loading Control (一抗) - WB,IHC-P,IHC-F,IF,Flow-Cyt,ICC/IF | Bioss

货号:bs-0061R
产品详情
相关标记
相关产品
相关文献
常见问题
概述
产品编号
bs-0061R
产品类型
内参抗体、胞质(包浆或全细胞)内参抗体、宠物抗体、农牧业/家禽抗体、水生生物抗体
英文名称
beta-Actin Rabbit pAb, Loading Control
中文名称
β-肌动蛋白/β-Actin(内参)抗体
英文别名
Bact; actin; BKRNS; BNS; BRWS1; CSMH; DDS1; PS1TP5BP1; THC8; Actx; E430023M04Rik; beta-actin; ACT-5; ACTB_CHICK; ACTB; 3.6.4.-; ACTB_BOVIN; ACTB_HORSE; ACTB_HUMAN; ACTB_MOUSE; ACTB_RABIT; ACTB_RAT; ACTB_SHEEP;
抗体来源
Rabbit
免疫原
Synthetic MAP peptide derived from human beta-Actin: 1-200/375
亚型
IgG
性状
Liquid
纯化方法
affinity purified by Protein A
克隆类型
Polyclonal
理论分子量
42 kDa
检测分子量
42 kDa
浓度
1mg/ml
储存液
0.01M TBS (pH7.4) with 1% BSA, 0.02% Proclin300 and 50% Glycerol.
研究领域
SWISS
Gene ID
保存条件
Shipped at 4℃. Store at -20℃ for one year. Avoid repeated freeze/thaw cycles.
注意事项
This product as supplied is intended for research use only, not for use in human, therapeutic or diagnostic applications.
产品介绍
内参抗体
β-Actin是横纹肌肌纤维中的一种主要蛋白质成分,也是肌肉细丝及细胞骨架微丝的主要成分。具有收缩功能,分布广泛,具有高度保守性,在细胞中的表达相对稳定,因此常被用作校正系统的内参。β-Actin分子量为42 kDa,
此抗体主要用于标记平滑肌及其来源的肿瘤。
β-Actin是横纹肌肌纤维中的一种主要蛋白质成分,也是肌肉细丝及细胞骨架微丝的主要成分。具有收缩功能,分布广泛,具有高度保守性,在细胞中的表达相对稳定,因此常被用作校正系统的内参。β-Actin分子量为42 kDa,
此抗体主要用于标记平滑肌及其来源的肿瘤。
背景资料
Actin is a highly conserved protein and an essential component of cell cytoskeleton and plays an important role in cytoplasmic streaming, cell shape determination, cell division, organelle movement and extension growth. Preferentially expressed in young and expanding tissues, floral organ primordia, developing seeds and emerging inflorescence. Antibodies against plant Actin are useful as loading controls for Western Blotting.

产品应用
| 应用 | 已检合格种属 | 预测种属 | 推荐稀释比例 |
|---|---|---|---|
| WB | Human, Mouse, Rat | Rabbit, Pig, Sheep, Chicken, Dog, Cat, Hamster, GuineaPig, Fish, Bee | 1:5000-50000 |
| IHC-P | Human, Mouse, Rat | Rabbit, Pig, Sheep, Chicken, Dog, Cat, Hamster, GuineaPig, Fish, Bee | 1:200-1000 |
| IHC-F | Human, Mouse, Rat | Rabbit, Pig, Sheep, Chicken, Dog, Cat, Hamster, GuineaPig, Fish, Bee | 1:200-1000 |
| IF | Human, Mouse, Rat | Rabbit, Pig, Sheep, Chicken, Dog, Cat, Hamster, GuineaPig, Fish, Bee | 1:200-1000 |
| Flow-Cyt | Human | Mouse, Rat, Rabbit, Pig, Sheep, Chicken, Dog, Cat, Hamster, GuineaPig, Fish, Bee | 1μg/Test |
| ICC/IF | Human | Mouse, Rat, Rabbit, Pig, Sheep, Chicken, Dog, Cat, Hamster, GuineaPig, Fish, Bee | 1:100-500 |
交叉反应
交叉反应: Human, Mouse, Rat (predicted: Rabbit, Pig, Sheep, Chicken, Dog, Cat, Hamster, GuineaPig, Fish, Bee)
相关产品
暂无相关产品
靶标
基因名
ACTB
蛋白名
Actin, cytoplasmic 1
亚基
Polymerization of globular actin (G-actin) leads to a structural filament (F-actin) in the form of a two-stranded helix. Each actin can bind to 4 others. Identified in a mRNP granule complex, at least composed of ACTB, ACTN4, DHX9, ERG, HNRNPA1, HNRNPA2B1, HNRNPAB, HNRNPD, HNRNPL, HNRNPR, HNRNPU, HSPA1, HSPA8, IGF2BP1, ILF2, ILF3, NCBP1, NCL, PABPC1, PABPC4, PABPN1, RPLP0, RPS3, RPS3A, RPS4X, RPS8, RPS9, SYNCRIP, TROVE2, YBX1 and untranslated mRNAs. Component of the BAF complex, which includes at least actin (ACTB), ARID1A, ARID1B/BAF250, SMARCA2, SMARCA4/BRG1, ACTL6A/BAF53, ACTL6B/BAF53B, SMARCE1/BAF57 SMARCC1/BAF155, SMARCC2/BAF170, SMARCB1/SNF5/INI1, and one or more of SMARCD1/BAF60A, SMARCD2/BAF60B, or SMARCD3/BAF60C. In muscle cells, the BAF complex also contains DPF3. Found in a complex with XPO6, Ran, ACTB and PFN1. Component of the MLL5-L complex, at least composed of MLL5, STK38, PPP1CA, PPP1CB, PPP1CC, HCFC1, ACTB and OGT. Interacts with XPO6 and EMD. Interacts with ERBB2.
亚细胞定位
Cytoplasm, cytoskeleton.
组织特异性
Ubiquitously expressed in all eukaryotic cells.
翻译后修饰
ISGylated.
Oxidation of Met-44 by MICALs (MICAL1, MICAL2 or MICAL3) to form methionine sulfoxide promotes actin filament depolymerization. Methionine sulfoxide is produced stereospecifically, but it is not known whether the (S)-S-oxide or the (R)-S-oxide is produced.
Oxidation of Met-44 by MICALs (MICAL1, MICAL2 or MICAL3) to form methionine sulfoxide promotes actin filament depolymerization. Methionine sulfoxide is produced stereospecifically, but it is not known whether the (S)-S-oxide or the (R)-S-oxide is produced.
疾病
Defects in ACTA1 are the cause of nemaline myopathy type 3 (NEM3) [MIM:161800]. A form of nemaline myopathy. Nemaline myopathies are muscular disorders characterized by muscle weakness of varying severity and onset, and abnormal thread-or rod-like structures in muscle fibers on histologic examination. The phenotype at histological level is variable. Some patients present areas devoid of oxidative activity containg (cores) within myofibers. Core lesions are unstructured and poorly circumscribed.
Defects in ACTA1 are a cause of myopathy congenital with excess of thin myofilaments (MPCETM) [MIM:161800]. A congenital muscular disorder characterized at histological level by areas of sarcoplasm devoid of normal myofibrils and mitochondria, and replaced with dense masses of thin filaments. Central cores, rods, ragged red fibers, and necrosis are absent.
Defects in ACTA1 are a cause of myopathy congenital with excess of thin myofilaments (MPCETM) [MIM:161800]. A congenital muscular disorder characterized at histological level by areas of sarcoplasm devoid of normal myofibrils and mitochondria, and replaced with dense masses of thin filaments. Central cores, rods, ragged red fibers, and necrosis are absent.
相似性
Belongs to the actin family.
功能
Actins are highly conserved proteins that are involved in various types of cell motility and are ubiquitously expressed in all eukaryotic cells.
同靶标产品
相关文献
提示: 发表研究结果有使用 bs-0061R 时请让我们知道,以便我们可以引用参考文章。作为回馈,资料提供者将获得我们送上的小礼品。
具体参考文献:bs-0061R 被引用于1730文献中